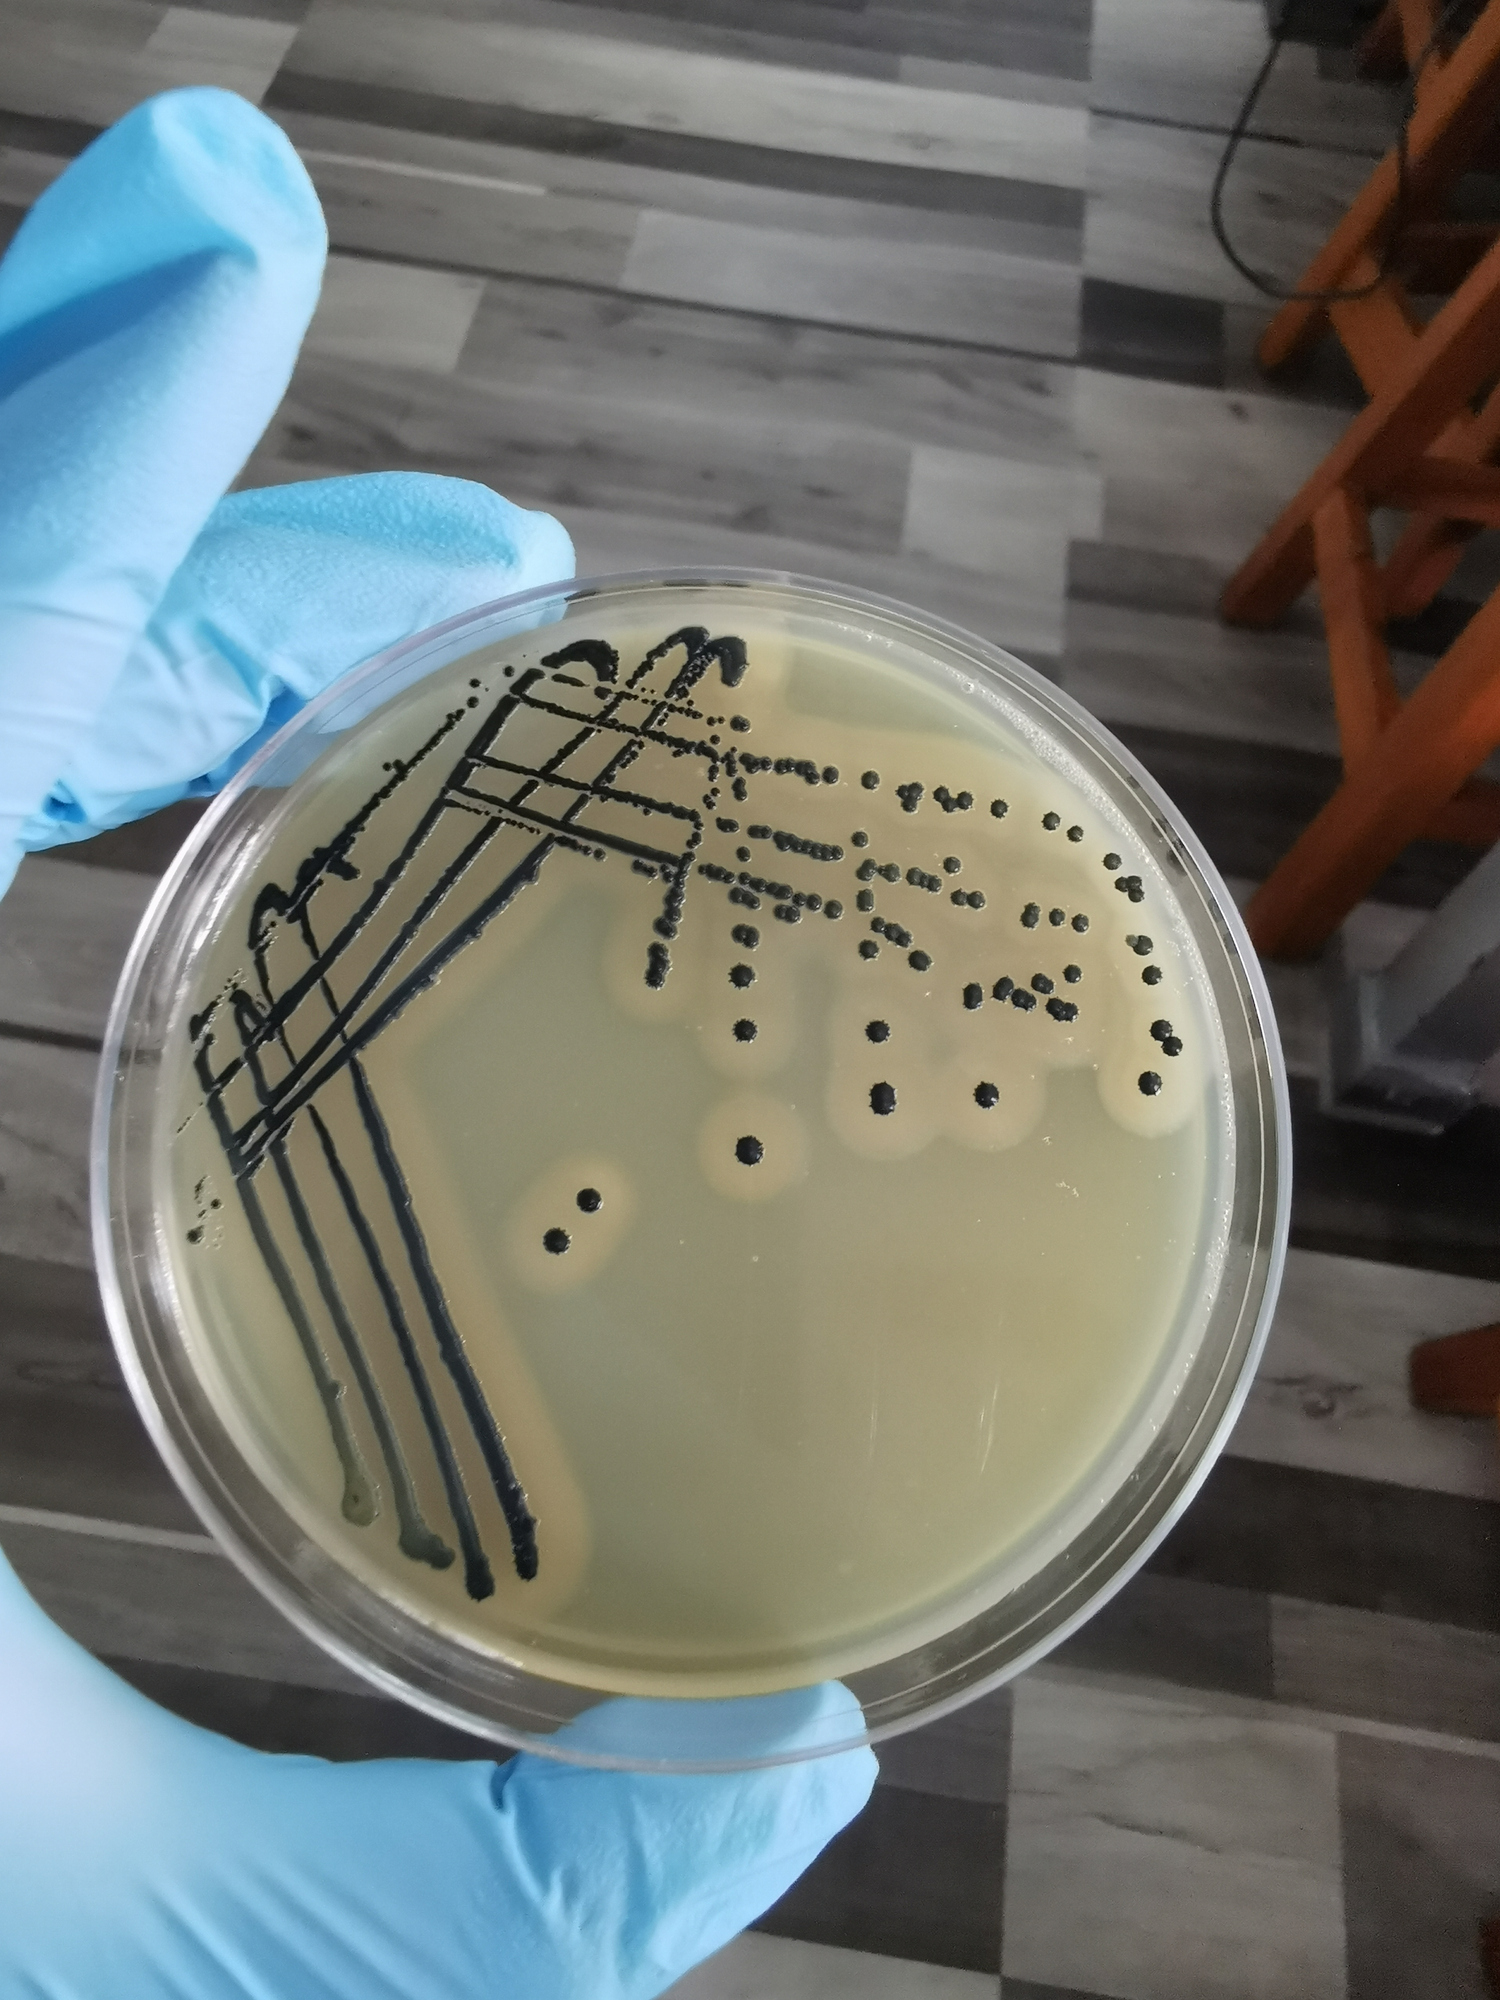
Staph Infection

Up to 30% of us carry the bacterium known as Staphylococcus aureus on our skin or in our nose…and in most cases, we’re not affected by its presence. But under certain conditions, it can cause a potentially deadly infection. We asked infectious disease specialist Jeremy D. Young, MD, of The Ohio State Wexner Medical Center, to explain what is a staph infection. “There are many Staphylococcus species, and several of them can cause infection. However, experts consider Staphylococcus aureus to be the most pathogenic, dangerous and harmful species,” he said. “Staphylococcus aureus can cause an infection anywhere in the body. We typically see skin and soft tissue infections, but people can have staphylococcal pneumonia, urinary tract infections, bloodstream infections, joint infections, and infections in other anatomic locations.” Staph infection symptoms differ depending on where the infection is.
Staph Infections of the Skin
Staph infections of the skin are the most common type of infection caused by the staph bacterium, and they can take many forms, such as impetigo with facial sores that crust over…folliculitis with pus-filled bumps around hair follicles…and boils, deeper pus-filled pockets in places like the groin and underarms.
“For skin infections, we look for redness, pain and warmth of the skin,” said Dr. Young. “Sometimes, there is draining pus if an abscess has formed. We also watch out for systemic symptoms, such as fevers and chills, signs of a more serious infection.”
Other Staph-Related Infections
Staphylococcus aureus becomes even more dangerous when it enters the bloodstream, which can happen through any type of break in the skin, even just a scratch. Having bacteria in your blood is called bacteremia, and it can lead to a blood infection that can quickly overwhelm your immune system—that response is called sepsis. Bacteremia symptoms can rapidly escalate from fever and chills to having a hard time breathing, a rapid heart rate, confusion and extreme pain. Without treatment for sepsis, you can develop septic shock, with plummeting blood pressure, organ failure and death.
The bacteria also can travel through the bloodstream to other parts of the body. Osteomyelitis is the bone infection caused by staph. Septic arthritis occurs when staph infects joints, both larger joints like the hips, knees and shoulders, and smaller joints in hands and feet. It even can attach to replacement joints. Symptoms often include swelling, severe pain and fever.
Pneumonia can develop from abscesses caused by staph bacteria in the lungs. When staph attaches to damaged or replacement heart valves, it causes endocarditis, or heart valve infection, which can lead to heart failure or stroke.
If you eat staph-contaminated food, you could experience staph-caused food poisoning with typical vomiting and diarrhea. One difference between staph and other food poisoning bacteria such as Salmonella is how quickly symptoms start, often within minutes rather than hours of eating the contaminated food.
The staph bacterium also is the source of toxic shock syndrome, when some staph strains cause the immune system to go into overdrive. Symptoms come on very quickly and include low blood pressure, high fever, nausea, confusion, muscle aches and sunburn-like skin discoloration. Toxic shock can rapidly progress to kidney failure and damage to other organs. While toxic shock syndrome has been linked to high-absorbency tampons, even low-absorbency ones can be a breeding ground, especially if left in for more than four to eight hours. It also has been linked to risk factors beyond menstruation, including a break in the skin from a cut or burn or surgery.
Getting Fast Medical Attention
“With every infection, there tends to be stages of clinical progression. A special characteristic of Staphylococcus aureus is that it can, indeed, progress very quickly,” said Dr. Young. “I have seen many patients go from being healthy in their homes to the intensive care unit within hours of a staphylococcal infection. Prompt diagnosis and treatment usually is warranted.” If you notice any symptoms that could indicate any form of staph infection, get medical help right away.
A physical examination, your medical history and possible tests are needed to make a diagnosis. “Sometimes we do have a particularly high suspicion for a staphylococcal infection. When someone has a cellulitis with draining pus or an area of necrotic skin, that often makes us think of Staphylococcus aureus specifically.”
A primary care provider usually can treat early-stage staph infections. But if the infection is severe or you’ve had it before, you should see an infectious disease specialist. Depending on what organs, bones or tissues are affected, you may need additional doctors, such as a cardiac surgeon for endocarditis.
Staph Infection Treatment
Treatment varies based on the type of infection. It usually includes antibiotics (the exception is staph-related food poisoning, which resolves on its own but requires hydration). For serious situations such as endocarditis, treatment can be aggressive, with IV drugs for a very long time. When a replacement heart valve or joint is affected, it may need to be surgically removed. Surgery also is sometimes necessary for osteomyelitis to remove dead bone.
There is growing concern over the effectiveness of some antibiotics used for staph infections. Like most bacteria, the more Staphylococcus aureus is exposed to antibiotics, the greater the chances it will become antibiotic-resistant. “Almost 50% of Staphylococcus aureus isolates, or strains, in the hospital are methicillin-resistant Staphylococcus aureus, or MRSA,” said Dr. Young. “We’ve become particularly concerned about the community transmission of MRSA, which can be a severe and antibiotic-resistant infection. MRSA infections have been contracted in gyms, military barracks and other places where humans tend to congregate and come into close contact.
“Thankfully, we do have antibiotics to treat most MRSA isolates—powerful anti-staphylococcal antibiotics such as vancomycin, daptomycin and linezolid. However, there have been reports of MRSA bacteria that are resistant to many of these drugs. Also, treatment can become complicated by antibiotic allergies, drug-drug interactions, antibiotic intolerance and drug resistance due to overuse. Therefore, treatment can be complex, but we are usually successful if we start treatment early.”
Know Your Staph Infection Risk
“Those most at risk for a staphylococcal infection of the skin include people with an injury to their skin,” Dr. Young explained. “This could be a wound, injection drug use, underlying eczema or psoriasis. Other risk factors are poorly controlled diabetes, edema due to impaired lymphatic or venous drainage, obesity, a preexisting skin infection and being immunocompromised. Examples of people who may be immunocompromised are those living with HIV, actively receiving chemotherapy or experiencing a suppressed immune system following an organ transplant.”
Steering Clear of Staph
Is staph infection contagious? Yes…staphylococcal infections can be spread by skin-to-skin contact, but the bacterium often is transmitted in places where people cluster together and touch common objects colonized with the organism, such as gyms and coffee bars, said Dr. Young. “Many people have Staphylococcus aureus on their skin and in their nose with no symptoms or any clinically apparent infection. So it can be contracted very easily by contact with a person or inanimate object colonized with Staphylococcus aureus.
“While some risk factors often cannot be avoided, such as having a deep IV line for hemodialysis or chemotherapy, for instance, people can take some basic steps to help avoid staph infections. The most helpful thing is to practice good hygiene, especially if you have come into contact with clusters of people. So, if you go to the gym, be sure to wipe down surfaces of equipment, wash your hands, shower afterward and try to avoid sharing personal items. If you have any open wounds, keep them clean and covered.”
Also keep in mind that you can become reinfected. “Having a previous staphylococcal infection does not make you immune to a subsequent infection with the same bacterial pathogen,” warned Dr. Young.